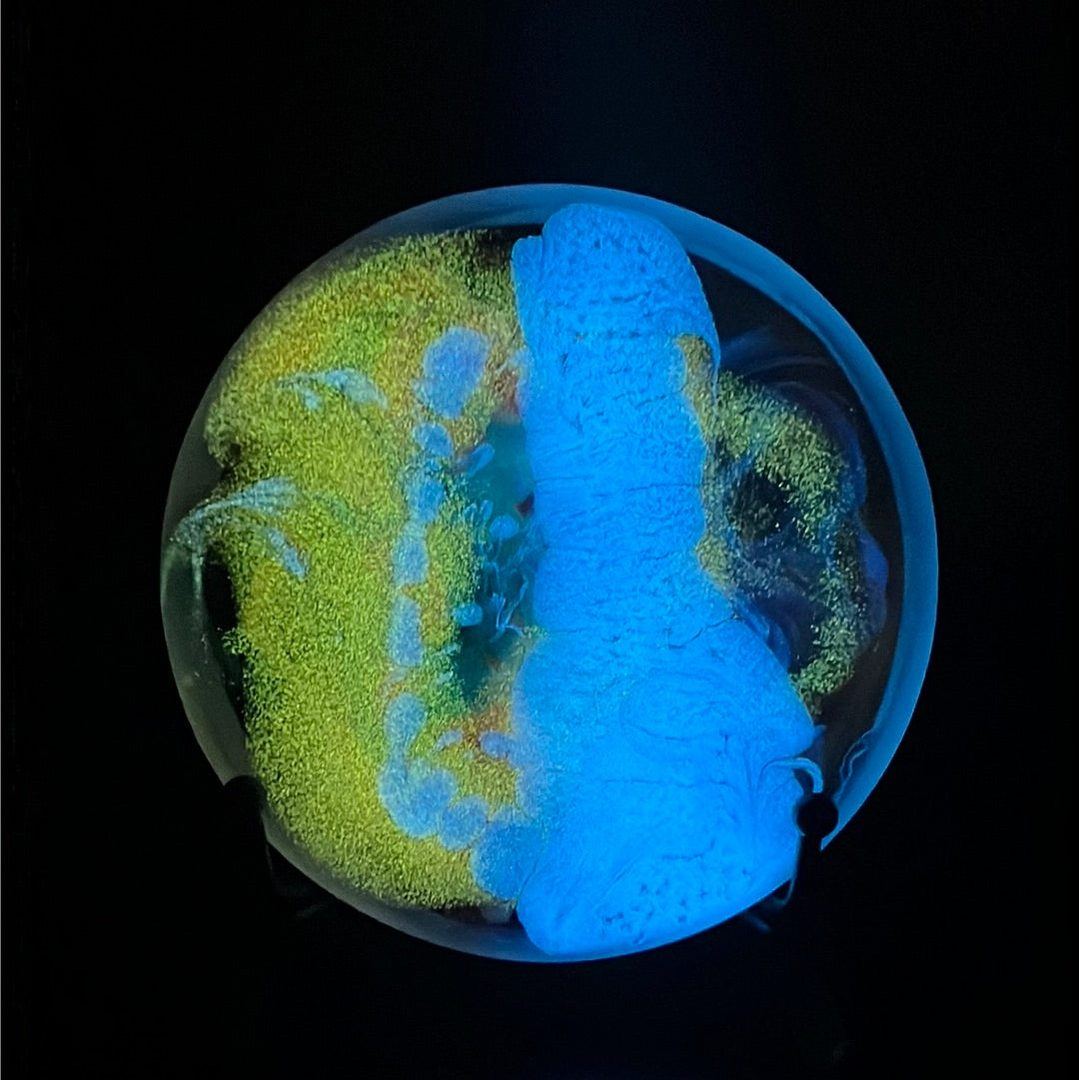

Custom Blue Glow Resin Mini - Exclusive "RAD Plague Doctor"
Custom Blue Glow Resin Mini - Exclusive "RAD Plague Doctor"
Det gick inte att ladda hämtningstillgänglighet
*Exclusive to Rare Air Discs, Wiser Hyzer has made glowing resign backdrops with a wooden "RAD Plague Doctor" design! These came out incredible - Four Pictures of each one!
Wiser Hyzer Minis are not your typical resin minis. Forged in the legendary Lab, these minis are both Epoxy and Urethane resin. Why? They are harder than standard epoxy, capable of glass-clear clarity. They are cured under 60 lbs of pressure using only the brightest glow and most elegant micas, these pieces of art will grace your bag for as long as you throw. That or until you make a nasty birdie and forget to pick it up. ***Warning, will draw jealousy from competitors and bring super powers of confidence
PDGA Approved Mini's